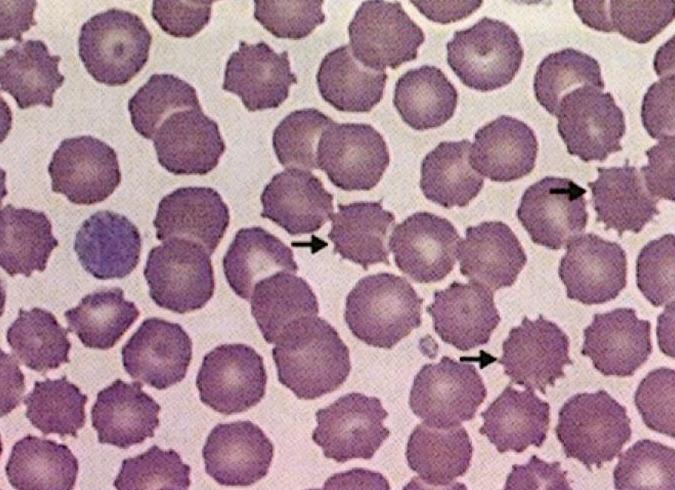
Эхиноциты в крови

[Эхиноциты в крови]
[Эхиноциты в крови]
Эхиноциты в крови причины
Многие годы пытаетесь вылечить ГИПЕРТОНИЮ?
Глава Института лечения: «Вы будете поражены, насколько просто можно вылечить гипертонию принимая каждый день…
Читать далее »
Недомогание, головная боль, тошнота и головокружение — признаки того, что артериальное давление достигло отметки 150 на 80. В критических ситуациях и при слабом здоровье рекомендуется немедленно обращаться к врачу. Если ситуация не слишком тяжелая, ситуацию можно исправить, не покидая дома.
О чем говорит давление 150 на 80
Показатели АД нужны для того, чтобы выявить силу и скорость работы сердца. Также это помогает определить объем крови, которое сердечная мышца перекачивает в минуту. Показатели АД зависят от состояния эндокринной и вегетативной нервной системы, поэтому повышение или понижение давления сигнализирует о том, что в одной из них или сразу в обоих произошел сбой.
НАШИ ЧИТАТЕЛИ РЕКОМЕНДУЮТ!
Для лечения ГИПЕРТОНИИ наши читатели успешно используют Норматен. Видя, такую популярность этого средства мы решили предложить его и вашему вниманию. Подробнее здесь…
В обозначении присутствуют два показателя: верхний – систолический и нижний – диастолический. Первый говорит о степени напряжения сердечной мышцы в момент выбрасывания крови. Нормой считаются пределы от 120 до 140 мм рт. ст. Диастолическое давление характеризует работу сосудов в момент, когда сердце расслаблено и не выталкивает кровь. Также оно сообщает о работе почек, которые вырабатывают ренин, повышающий тонус кровеносных сосудов. Нормальное диастолическое давление – от 70 до 90 мм рт.ст.
Между систолическим и диастолическим показателем должна быть определенная разница, норма которой составляет не более 30-50 мм рт. ст.
При давлении 150 на 80 разница составляет 70 мм. Это говорит о том, что сердечная мышца перекачивает кровь сильнее, чем нужно и быстрее стареет. Показатели 150 на 80 относятся к отклонению — в этом случае человек уже нуждается в медицинской помощи.
Нормальные значения могут отличаться в зависимости от возраста. В 60 лет нормальным считаются показатели: 140 мм рт.ст. на 90 мм рт.ст. Отклонения индивидуальны и зависят от состояния организма.
Причины повышенного артериального давления
У детей и подростков АД повышается редко – это связано с тем, что организм в этом возрасте более крепкий, менее подвержен влиянию окружающей среды и хронических заболеваний. С возрастом артериальное давление почти всегда становится выше. На это влияет совокупность следующих факторов:
- Возрастные изменения;
- Хронические патологии почек, печени, сердца и других внутренних органов и систем;
- Снижение тонуса кровеносных сосудов;
- Частое употребление энергетических напитков, обладающих тонизирующими свойствами;
- Ненормированные физические нагрузки (или занятия спортом прямо перед измерением показателей);
- Физическое и эмоциональное переутомление, бессонница, частые стрессы, нервозность и повышенная тревожность;
- Генетическая предрасположенность;
- Неконтролируемый прием лекарственных средств, помогающих справиться с пониженным давлением;
- Переизбыток жирных кислот, нездоровое питание;
- Полное отсутствие физических нагрузок;
- Злоупотребление спиртными напитками и табачной продукцией;
- Нарушения в работе надпочечников, поджелудочной железы и почек.
В число возможных факторов входят причины, не связанные с заболеваниями или образом жизни. Сюда относится неправильное поведение во время измерения, неправильная поза и время замера. Ложные результаты могут быть в том случае, если человек не соблюдает технику измерения артериального давления.
До определенного момента человек может даже не подозревать о повышенном давлении. Как только скорость и сила работы сердца достигнет определенных показателей, у пациента начнут проявляться следующие симптомы:
- Повышенная тревожность, страхи;
- Шум в ушах;
- Усиленное отделение пота;
- Боль в голове, головокружение, тошнота;
- Ощущение сдавленности и боли в грудной клетке;
- Одышка при отсутствии физического напряжения;
- Помутнение зрения (потемнение в глазах);
- Покраснение кожи;
- Повышенная температура, слабость;
- Холод в конечностях.
Лечение повышенного артериального давления
Препараты для снижения высокого АД делятся на несколько основных групп:
- Диуретики. Это категория препаратов, которые напрямую или косвенно воздействуют на печень, повышая интенсивность ее работы и выделение желчи. Также они уменьшают всасываемость солей и воды, стимулируя ее выведение вместе с водой. Главный фармакологический эффект – мочегонный. К препаратам этой группы относятся: Арифон (323 р), Меркузал (340 р), Спиронолактон (45 р).
- Антагонисты кальция. Блокируют проникновение кальция в сердце и кровеносные сосуды по специфическим кальциевым каналам. Уменьшают напряженность сердечной мышцы. Назначаются при заболеваниях органов кровообращения. К антагонистам кальция относятся: Амлопидин (12 р), Нифедипин (от 12 р), Коринфар (87 р).
- Бета-блокаторы. Группа лекарств от гипертонии. Воздействуют на симпатическую нервную систему. К бета-блокатором относятся Бисопролол (42 р), Бипрол (90 р), Небилет (462 р).
Также назначаются ингибиторы АПФ и сартаны. Беременным женщинам прописываются Папазол и Кордафлекс.
Перед применением перечисленных выше препаратов внимательно ознакомьтесь со списком компонентов, противопоказаниями и инструкцией по применению.
Низкий пульс (брадикардия) не всегда возникает на фоне серьезных патологий. Иногда такое состояние может иметь чисто физиологическое происхождение. Но часто именно снижение частоты сердечного ритма – первый признак многих тяжелых заболеваний. О чем может свидетельствовать низкий пульс – выясним причины и что делать для устранения патологии.
- Причины брадикардии
- Признаки
- Низкий пульс при низком давлении – что делать
- Сниженный сердечный ритм при повышенном АД – что делать
- Как повысить пульс
- Что делать в домашних условиях
| Низкий пульс при нормальном давлении: как повысить сердечный ритм |
| Пульс у беременных: таблица нормы |
| Причины и симптомы учащенного пульса при нормальном давлении |
| Что делать при пульсе 100 ударов в минуту? |
Пульс меняется под влиянием различных факторов, в том числе температуры тела и воздуха, эмоционального состояния. Частота сердечного ритма зависит от возраста. Например, максимальные показатели бывают у детей дошкольного возраста – более 100 уд/мин. С возрастом пульс понижается – у пожилых людей он самый низкий. Пониженный сердечный ритм всегда бывает и у профессиональных спортсменов.
Какой показатель считается низким? Брадикардию диагностируют при регулярном снижении сердечного ритма ниже 55 уд/мин. Патология часто свидетельствует о наличии различных заболеваний. Брадикардия бывает экстракардиальной и органической.
Когда возникает экстракардиальная брадикардия:
- частый признак вегето-сосудистой дистонии;
- неврозы;
- опухоли, ушибы мозга, менингит;
- почечные колики;
- гипотиреоз;
- курение.
Часто пульс снижается у людей, которые голодают, применяют монодиеты. Снижается количество сердечных сокращений и при сильном давлении на сонную артерию. Органическая брадикардия развивается на фоне кардиосклероза, инфаркта, приема некоторых лекарств.
Очень низкий пульс (менее 40 уд/мин) свидетельствует о сильной интоксикации, которая возникает при сепсисе, вирусном гепатите, тифе. Сильно снижается сердечный ритм при повышенном содержании в крови кальция и калия, при отравлении фосфатами, продуктами распада белка.
У ребенка брадикардия может иметь физиологический характер – пульс снижается во время сна и покоя, после длительного пребывания в холодной воде или помещении. При отсутствии внешних раздражителей уменьшение частоты сердечных сокращений чаще всего вызвано повышенным тонусом блуждающего нерва, что бывает при проблемах с сердечной мышцей.
У подростков пульс снижается из-за быстрого увеличения размеров сердца, на фоне гормональной перестройки и нарушенного обмена веществ, переутомления.
Почему низкий пульс опасен? При брадикардии мозг и внутренние органы испытывают постоянный дефицит кислорода, что может стать причиной развития необратимых патологических состояний. Снижение сердечного ритма ниже 30 уд/ мин может привести к обмороку. Наиболее опасные осложнения – отек мозга, кома, остановка сердца.
Признаки
Незначительное снижение частоты сердечных сокращений практически никак не отражаются на самочувствии. При снижении пульса ниже отметки 50 уд/мин состояние человека может резко ухудшиться.
Симптомы брадикардии:
- болит голова, начинается сильное головокружение;
- человек становится вялым, появляется слабость;
- полуобморочное состояние, возможна потеря сознания;
- боль в грудине, одышка;
- аритмия.
Если снижение сердечного ритма вызвано проблемами со щитовидной железой, то к основным признакам добавляется тремор пальцев, мышечная слабость, человек резко теряет вес.
При сердечных патологиях низкий пульс сопровождается повышенной утомляемостью, которая не проходит даже после полноценного отдыха, увеличивается потоотделение, отекают конечности.
Низкий пульс при низком давлении – что делать
Гипотония в сочетании с низким пульсом – частый признак серьезных болезней, иногда такое состояние опасно для жизни.
Причины подобного состояния:
- инфаркт – снижается диастолическое давление, возникает сильная боль за грудиной;
- тромбоэмболия легочной артерии;
- анемия, неврозы, нарушение обменных процессов – часто сопровождаются обмороками и коллапсом;
- сильная кровопотеря, кровотечения;
- отек Квинке;
- инфекции, интоксикация.
При гипотонии и низком пульсе не следует спешить принимать лекарственные препараты. Иногда достаточно прилечь, выпить зеленый чай или крепкий натуральный кофе с сахаром. Если самочувствие позволяет, можно пройтись пешком быстрым шагом или сделать небольшую зарядку.
Сниженный сердечный ритм при повышенном АД – что делать
При незначительном снижении показателей пульса человек ощущает только симптомы высокого давления – мигрень, звон в ушах, одышка, тошнота. При этом кожные покровы покрываются красными пятнами, возникают приливы жара. Если пульс снижается ниже 50 уд/мин, то начинается головокружение, возможна потеря сознания.
Почему снижается пульс при гипертонии:
- сердечные патологии – эндокардит, порок сердца, ишемия, кардиосклероз;
- вегето-сосудистая дистония;
- разного рода опухоли;
- эндокринные болезни, гормональные колебания;
- умственные и физические перегрузки.
Иногда брадикардия – побочный эффект после приема лекарственных препаратов для нормализации давления.
[/idea]Важно! Если высокое артериальное давление сопровождается брадикардией, то не следует принимать никаких лекарственных препаратов до приезда врачей – это может только усугубить ситуацию.[/idea]
При внезапном приступе брадикардии у гипертоника необходимо вызвать врача. До приезда скорой помощи на поясничный отдел, внешнюю поверхность икры или заднюю поверхность шеи можно приложить теплый компресс.
Как повысить пульс
Для определения причины брадикардии делают электрокардиографию, УЗИ сердца, биохимический и гормональный анализ крови. Лечение патологи проводят в условиях стационара, а основу терапии составляют инъекции и капельницы – Атропин, Алупент, Изадрин, Изопротеренол.
При частых приступах брадикардии назначают Ипратропиум – препарат нормализует работу гормональных желез, оказывает влияние на работу головного мозга, начинает действовать уже через 1,5 часа. При глаукоме и проблемах с органами пищеварения используют Орципреналин.
Если низкая частота пульса не сопровождается высоким давлением и нет серьезных сердечных заболеваний, можно принять природные стимуляторы и энергетики.
Что принимать при низком пульсе:
- настойка элеутерококка;
- экстракт гуараны или женьшеня;
- кофеин в таблетках, Аскофен;
- Изадрин;
- Адреналин, Эфедрин.
Если медикаментозная терапия не помогает улучшить самочувствие и пульс не поднимается выше 40 уд/мин, то требуется оперативное вмешательство – под большую грудную мышцу вшивают электрокардиостимулятор, который нормализует сердцебиение.
Что делать в домашних условиях
Повысить сердечный ритм можно при помощи теплой ножной ванночки, хорошо помогают горчичники, которые нужно ставить на воротниковую зону.
Первая помощь при резком приступе брадикардии:
- дать вдохнуть нашатырь;
- приподнять ноги выше головы;
- при необходимости сделать искусственное дыхание;
- вызвать скорую помощь.
Хорошо помогает настойка женьшеня – смешать 25 г измельченного корня сухого растения с 10 г красавки, залить смесь 1,5 л водки. Убрать настой в темное место на 21 день. Лекарство следует принимать по 15 капель трижды в сутки за полчаса до приема пищи. Продолжительность лечения – 3 месяца.
Для приготовления эффективного лекарства для лечения брадикардии потребуется всего 3 компонента – чеснок, мед и лимон. Выжать сок из 10 лимонов, добавить 10 измельченных головок чеснока и 1 л жидкого меда. Настоять смесь 10–12 дней, принимать по 40 г лекарства каждое утро до завтрака – порцию следует медленно рассасывать не менее 1 минуты.
При лечении сниженного пульса дома необходимо придерживаться здорового питания – в рационе должно быть больше морской капусты, жирной рыбы, орехов, блюд с перцем.
Чтобы избежать проблем с сердечным ритмом, необходимо больше двигаться, избавиться от пагубных привычек, высыпаться. Основу питания должна составлять здоровая еда – сезонные овощи и фрукты, рыба, молочная продукция. Только внимательное отношение к собственному здоровью поможет избежать развития серьезных заболеваний.
Пойкилоцитоз эритроцитов: понятие, степени, виды и причины
Анизоцитоз представляет собой патологическое изменение метрических параметров (размера) красных клеток крови — эритроцитов. Однако в клинической лабораторной диагностике существует и другое понятие, несколько схожее по звучанию или образуемое одно сложное слово с анизоцитозом — пойкилоцитоз (анизопойкилоцитоз).
Название «пойкилоцитоз» принадлежит эффекту образования и присутствия в крови патологически измененных эритроцитов, которые в результате каких-то происходящих в организме больного процессов потеряли свой естественный «облик» (круглую форму), а вместо этого приобрели несвойственные им очертания (груша, серп, эллипс и т. п.). Причем клетки, изменившие свой вид (часто до неузнаваемости), заодно утратили некоторые (как правило, основные) свойства и навыки. Например, ввиду такого ненормального для красных кровяных телец состояния, они перестают качественно решать задачи, вмененные им в обязанности (перенос кислорода от легких к тканям и транспорт отработанных продуктов — СО2, в обратном направлении).
От незначительного до выраженного – цифры, слова и плюсики
Пойкилоцитоз в общем анализе крови обнаруживается с помощью оптики (микроскоп) в ходе морфологического исследования мазка крови. Автоматическому анализатору подобная функция не под силу, клетки с пойкилоцитозом он просто отнесет к популяции эритроцитов, хотя при вычислении эритроцитарных индексов, скорее всего, проявится анемический синдром, поэтому после качественного (морфологического) анализа мазка в заключении появится запись: «Анизопойкилоцитоз» (с указанием формы эритроцитов).
Пойкилоцитоз в общем анализе крови может иметь процентное (%), числовое в баллах (1, 2, 3, 4), словесное выражение или обозначаться с помощью плюсов (+), например:
- Незначительный пойкилоцитоз — присутствие в мазке от 25 до 50% красных клеток крови, которые отличаются от нормальных по форме, или 1, или +;
- Умеренный пойкилоцитоз — от 50 до 70% клеток отличаются от нормальных эритроцитов по форме или 2, или ++;
- Выраженный пойкилоцитоз — от 70 до 75% эритроцитов имеют отличия по форме или 3, или +++;
- Резко выраженный пойкилоцитоз — до 100% кровяных телец не укладываются по форме в характеристики нормальных эритроцитов, 4 или ++++.
Для наглядности данные можно отразить в таблице:
| Незначительный (легкий) пойкилоцитоз | 25 – 50% | 1 | + |
| Умеренно-выраженный пойкилоцитоз | 50 – 70% | 2 | ++ |
| Высокая степень выраженности пойкилоцитоза | 70 – 75% | 3 | +++ |
| Резко выраженный пойкилоцитоз | До 100% | 4 | ++++ |
Кроме перечисленных обозначений, врач, обнаруживший изменение формы эритроцитов, должен указать вид пойкилоцитоза (микросфероцитоз, анулоцитоз, овалоцитоз и т. п.) или указать, какие формы клеток преобладают в мазке, чтобы помочь лечебникам определить направление дальнейшего обследования пациента.
Получив на руки и увидев незнакомое слово «пойкилоцитоз» или услышав его в кабинете врача при интерпретации результатов гемограммы, пациент, беспокоясь о своем здоровье, естественно, заинтересуется неведомым ранее термином, а особо мнительные вообще нарисуют картину тяжелого онкологического процесса – это случается чаще всего. Чтобы подобного не произошло, читателю полезно будет знать, что представляет собой это понятие, что там творится с эритроцитами, ибо цифры, плюсики и неизвестные слова несут информацию только врачу, а больного оставляют в неведении. Между тем, этот пробел можно заполнить, если все подробно рассказать и объяснить, что мы и попытаемся сделать в ходе дальнейшего изучения патологического изменения красной крови.
Двояковогнутая форма – зачем она нужна красным клеткам?
Безъядерные форменные элементы крови (эритроциты – Er), наполненные красным кровяным пигментом – гемоглобином (Hb), представляя собой двояковогнутые диски с небольшим просветлением в центре (оно занимает около трети площади всей клетки), несут очень важные для организма функции, выполнение которых обеспечивает именно эта конфигурация. Благодаря ей эритроциты могут в значительной степени изменять свою площадь поверхности, просачиваться в самые узкие по диаметру кровеносные сосуды, если того потребуют обстоятельства. Эта особенность эритроцитов очень важна для осуществления газообмена, ведь красным клеткам приходится доставлять кислород в самые труднодоступные места и оттуда же забирать углекислый газ. Понятно, что любая деформация эритроцитов нарушает привычное течение событий (газообмен) и становится препятствием на пути к выполнению функциональных обязанностей, что, естественно, скажется на здоровье многих органов и самочувствии человека.
Ввиду того, что понятие «пойкилоцитоз» не подразумевает приобретение какой-то одной (конкретной) формы вместо нормальной, а предполагает целый ряд изменений, в мазке крови можно встретить самые разные конфигурации красных кровяных телец. Форма эритроцитов в обязательном порядке должна быть указана в бланке результатов, ибо короткая запись, ограничивающаяся одним словом «пойкилоцитоз» вряд ли устроит лечащего врача.
Виды пойкилоцитоза складываются из присутствия и преобладания тех или иных патологически измененных форм эритроцитов. Названия видов также происходят от слов, которые определяют форму деформированных красных клеток крови, например: овалоциты – овалоцитоз, сфероциты – сфероцитоз, сфероциты с микроцитозом (уменьшенные в размерах клетки) – микросфероцитоз, шизоциты – шизоцитоз и так далее. Для того чтобы не повторяться, целесообразно затронуть некоторые виды пойкилоцитоза, опираясь на приобретенные клетками формы, то есть, вкратце описать, как выглядят и что собой представляют «пострадавшие» от какой-то патологии красные кровяные тельца.
Варианты изменения формы эритроцитов
Приобретение формы эритроцитами не свойственной им формы находится в корреляционной зависимости от определенной патологии. При морфологическом исследовании мазка крови можно обнаружить различные варианты видоизменений и деформации красных кровяных телец (виды пойкилоцитоза):
- Анулоциты – напоминающие пустые колечки образования, непохожие на настоящие красные клетки крови, нередко отмечаются при выраженном дефиците железа в организме;
- Сфероциты – эти клетки отличает шаровидная форма и уменьшенный размер (d ≈ 4 – 6 микрон), срединное просветление у них не просматривается. Такие эритроциты появляются при различных патологических состояниях (гемолитическая анемия Минковского-Шоффара – наследственный микросфероцитоз, анемический синдром, ставший следствием обширных ожогов, АВ0-несовместимые гемотрансфузии, ДВС-синдром, искусственные сердечные клапаны и пр.);
- Овалоциты, их еще по-другому называют эллиптоцитами – клетки имеют характерную форму эллипса, присутствуют у здоровых людей в количестве, не превышающем 10%, значительно «размножаются» при наследственном овалоцитозе, некоторых талассемиях и анемическом синдроме, обусловленном лейкозом;
- Планоциты или лептоциты – уплощенные или вовсе плоские клетки, характерны для железодефицитной анемии, отдельных гемоглобинопатий;
- Мишеневидные эритроциты (кодоциты) — из-за скопления красного пигмента крови по центру клетки наблюдается образование, напоминающее мишень. Подобного рода клетки свойственны для ЖДА, ДВС-синдрома, хронической алкогольной интоксикации и многих гемоглобинопатий (талассемий);
- Дакриоциты – слезовидные клетки-капельки, появляющиеся в мазке вследствие серьезных поражений паренхимы печени (токсический гепатит) или тяжелого железодефицитного состояния;
- Акантоциты отличаются зубчатой формой, характерны для наследственного акантоза, печеночной патологии, гемолитической анемии, алкоголизма и состояний после удаления селезенки;
- Шизоциты (мелкие) и кератоциты (более крупные, шлемовидные) – не клетки вовсе, а их фрагменты, оставшиеся после распада эритроцитов. Фрагментированные эритроциты могут появляться в случае тяжелого течения анемии, при ДВС-синдроме, васкулитах, злокачественной гипертензии, после протезирования клапанов сердца, а также при гемолитико-уремическом синдроме;
- Эритроциты в форме серпа (серповидные кровяные тельца или, как их еще называют, дрепаноциты) являются характерным признаком серповидно-клеточной анемии, однако в обычном препарате обнаружить такие клетки не удается, даже если они массово «заселяют» мазок. Находят серповидные эритроциты путем создания искусственной гипоксии на стекле, в условиях которой они себя хорошо проявляют;
- Стоматоциты (или гидроциты) – названы так, поскольку срединное просветление в центре клетки имеет форму изогнутой линии, похожей на рот. Подобные эритроциты отмечаются после гемотрансфузий, при поражениях печени (цирроз) и алкогольной интоксикации. Стоматоцитами представлены «взрослые» клетки эритроидного ряда в случае дефекта структурных белков мембраны Er — наследственного стоматоцитоза, протекающего с анемией, распадом красных кровяных телец в селезенке и изменением их формы;
- Эхиноциты (клетки-шары, снабженные многочисленными выростами), причиной их появления в мазке крови выступает тяжелая патология: гемолитико-уремический синдром, поражение печеночной паренхимы, рак желудка.
Вот такое разнообразие клеток, определяющее различные виды пойкилоцитоза, может предоставить для исследования красная кровь. Правда, они появляются не все разом – каждая форма характерна для определенного патологического состояния, хотя есть варианты болезней, при которых можно ожидать присутствие нескольких видов патологически измененных эритроцитов.
Причины появления пойкилоцитоза в общем анализе крови
Термин «анизопойкилоцитоз» не представляет собой отдельную нозологическую форму. Подобное явление можно наблюдать лишь в качестве лабораторного признака, сопровождающего различные, преимущественно, анемичные состояния, вызванные любым этиопатогенетическим фактором, и патологические процессы, которые в тот или иной период времени (или хронически) проходят в организме больного. В связи с этим причиной формирования пойкилоцитоза в общем анализе крови может быть довольно внушительный ряд заболеваний (гематологических и не только):
- Дефицит в организме такого важного химического элемента, как железо (Fe) по причине его недостаточного поступления с пищей (диеты), нарушенного всасывания (патология желудка и кишечника), повышенной потребности (вынашивание ребенка, кормление грудью, возраст активного роста и развития). Для железодефицитных состояний, протекающих в тяжелой форме, анизопойкилоцитоз и гипохромия относятся к характерным признакам болезни;
- Витаминная недостаточность (в первую очередь, дефицит витаминов группы В — В12, В9 — фолиевая кислота);
- Наследственная патология (гемолитические анемии и другие болезни крови);
- Метастатическое поражение главного кроветворного органа – костного мозга, миелодиспластические синдромы (для данной патологии наиболее характерно появление в крови клеток, отличающихся между собой не только размерами, но и формой);
- Инфекционные заболевания, протекающие с тяжелой интоксикацией (транзиторное проявление пойкилоцитоза);
- Диффузные поражения печеночной ткани и паренхимы поджелудочной железы;
- Гемолитико-уремический синдром – тяжелая патология, обусловленная воздействием многих неблагоприятных факторов и проявляющаяся сочетанием гемолитической анемии и тромбоцитопении не иммунного характера с острой почечной недостаточностью (ОПН);
- Протезирование клапанов сердца;
- Состояния после гемотрансфузий, особенно, несовместимых по системе АВ0.
В принципе, изменению формы (пойкилоцитоз) и метрических параметров (анизоцитоз) способна подвергаться любая клетка крови (это ее реакция на неблагоприятные условия, в которых ей приходится функционировать), кроме эозинофилов, поэтому круг причин, заставляющих эритроциты видоизменяться до неузнаваемости, конечно, шире.
Оценка эритроцитов в мазках крови — Зооинформ
Н. Пулетти
Оценка состояния эритроцитов — важный этап в исследовании мазков крови. При системном подходе она даёт исследователю много информации.
Микроскопия эритроцитов является дополнительным анализом при подсчёте количества клеток и формулы крови, который важно учитывать при постановке диагноза. В определённых случаях одна только оценка эритроцитов позволяет поставить конкретный диагноз.
Распределение эритроцитов оценивается в тонком слое мазка крови (таблица). В этой зоне клетки наиболее часто располагаются изолированно, что позволяет легко уточнить плотность их распределения. У животного с умеренной или тяжёлой анемией в сравнении со здоровым плотность распределения эритроцитов в тонком слое, как правило, чётко снижена (большое пространство между клетками) (фото 1а и 1б). В этой зоне мазка могут выявляться агглютинированные эритроциты и «монетные столбики» (фото 2 и 3). Очень важно дифференцировать «монетные столбики» от агглютинации, потому что их значимость сильно различается. Агглютинация объясняется присутствием иммуноглобулинов (в основном IgM), связанных с поверхностью эритроцитов и преимущественно персистирующих во время гемолитической анемии, опосредованной иммунным ответом (иммунная гемолитическая анемия — ИГА) (D.J. Weiss, 2000). Образование «монетных столбиков» обычно вторично и связано с увеличением концентрации белков, в частности глобулинов, встречаемом при воспалительных процессах (инфекционном перитоните у кошки, эрлихиозе и т. д.) или при неоплазии (множественная миелома или лимфома). Для дифференциации используется солевой тест (приложение). У кошек формирование «монетных столбиков» преимущественно физиологично, тогда как у собак оно чаще всего свидетельствует о наличии патологии.
Таблица. Исследование эритроцитов: оценка, распределение их размера, их формы и окраски
|
Плотность |
Размер |
Форма |
Цвет |
Включения, паразиты |
| Снижение: анемия | Макроцитоз: регенеративная анемия,
лейкоз кошки и т.д. Микроцитоз: дефицит по содержанию железа, порто-системное шунтирование |
Акантоциты, шизоциты, кератоциты: гемангио-саркома, ДВС* синдром и т.д.Сфероциты: гемолиз опосре-дованный иммунной реакцией
Эхиноциты: часто артефакт |
Гипохромия: дефицит железа | Тельца Гейнца, эксцентро- циты: окислительное повреждениеТельца Говелла-Жолли: регенеративная анемия и т.д.
Паразиты: Babesia canis, Mycoplasma hoemofelis |
| *ДВС — диссеминированное внутрисосудистое свёртывание |
| Фото 1а и 1б. Считывание мазков крови под микроскопом (× 500). Тонкий слой мазка у здоровой собаки. 1а — сопоставимый с анемичной собакой. 1б — во втором мазке количество эритроцитов менее выраженное |
| Фото 2. Считывание мазка крови под микроскопом (× 500) у собаки, подверженной гемолитической анемии, опосредованной иммунной реакцией. Следует обратить внимание на агглютинацию эритроцитов | Фото 3. Считывание мазка крови под микроскопом (× 1000) у здоровой собаки. Эритроциты представлены в форме монетных столбиков |
Увеличение размера
Макроциты — эритроциты большого размера, превышающего размер зрелых эритроцитов. Макроциты, обычно с наличием полихроматофилии, обнаруживают при регенеративной анемии (вариацию объёма эритроцитов называют анизоцитозом).
Полихроматофилы распознают по слегка базофильному цвету, что объясняется наличием рибосом, окрашивающихся в голубой цвет (фото 5) (N.C. Lain, 1993). С практической точки зрения у собаки или кошки, страдающих анемией, независимо от степени её выраженности, обнаружение двух четвертей полихроматофилов в поле зрения микроскопа (х1000) можно считать признаком регенерации. Подсчёт ретикулоцитов (эритроциты характерной окраски при окрашивании новым метиленовым синим c присутствием агрегированных или изолированных темно-голубых включений в их цитоплазме) считается стандартным методом на определение регенеративной анемии (фото 6). Однако в системе гемоциркуляции и здоровых собак и кошек выявляется небольшое количество этих клеток, соответствующее приблизительно одному полихроматофилу на 100–200 эритроцитов. Макроцитоз может проявляться не только при регенеративной анемии. Но в этих случаях при анизоцитозе полихроматофилии не обнаруживают. У кошек, заражённых вирусом лейкоза (FeLV), часто отмечают персистенцию вторичных макроцитов с дисэритропоэзом, который провоцируется вирусом. Это вирусное заболевание может сопровождать анемия, регенеративная или нет (в зависимости от стадии развития заболевания). Описаны случаи физиологического макроцитоза у борзых и некоторых миниатюрных пуделей (C.J. Kociba, 2000).
Снижение размеров
Микроциты (эритроциты малого размера) выявляют при анемии, вызванной дефицитом железа (алиментарный дефицит, хронические кровотечения), секвестрации железа в крови (при синдроме воспаления, впрочем, секвестрация железа часто ведёт к нормоцитарной нормохромной анемии), портосистемном шунтировании и, что наиболее странно, могут быть вариантом нормы у некоторых пород собак, таких как акита-ину (J.W. Harvey, 2000).
| Фото 4. Визуализация под микроскопом (× 200). Солевой тест позитивный, основывающийся на персистенции агглютинации эритроцитов у собаки | Фото 5. Считывание мазков крови под микроскопом у здоровой собаки (× 1000). Диагностирована полихроматофилия |
| Фото 6. Считывание мазка крови под микроскопом у анемичной собаки (× 1000). Отмечается персистенция ретикулоцитов (при наличии включений тёмно-голубого цвета в цитоплазме) после окраски новым голубым метиленовым | Фото 7. Считывание мазка крови под микроскопом (× 500) у собаки, подверженной гемолитической анемии, опосредованной иммунной реакцией. Следует обратить внимание на наличие большого количества сфероцитов (стрелочки) |
Сфероциты
Сфероциты — это эритроциты малого размера, которые при сравнении их в тонком слое мазка с другими эритроцитами имеют более интенсивную окраску без признаков просветления в центре (фото 7). Эритроциты у основания мазка крови, естественно, более плотные и без признаков просветления в центральной их части, можно спутать со сфероцитами.
У собак сфероциты, часто в сочетании с агглютинацией, обычно обнаруживают при иммунной гемолитической анемии (более чем у 80% больных собак присутствует выраженный сфероцитоз и более чем у 30% при этом отмечается агглютинация). О сфероцитозе в основном говорят, когда в поле зрения микроскопа отмечают более 20% сфероцитов.
У кошки, несмотря на то что иммунная гемолитическая анемия встречается очень редко, сфероциты трудно дифференцировать от эритроцитов, потому как, последние в центральной их части не имеют просветления.
Акантоциты
Акантоциты — эритроциты, которые при анализе их под световым микроскопом имеют плотную цитоплазму, а также неодинаковую по длине и ширине поверхность мембраны (фото 8). Их формирование может иметь вторичную природу в связи с увеличением соотношения в мембране холестерина к фосфолипидам при гиперхолестеринемии, липидозе печени или при холангиогепатите у кошек, а также в случае портосистемного шунтирования у собак. Формирование акантоцитов может также вызвать микроангиопатия, провоцирующая нарушение эритроцитов (ДВС-синдром, гемангиосаркома, гломерулонефрит и т. д.) (D.J. Weiss, 2000).
Кератоциты и шизоциты
Кератоциты — это эритроциты, которые имеют две проекции острых конвергентных (встречающихся) краёв, соединяющихся на одном конце клетки (фото 9). Шизоциты имеют сильно повреждённую структуру и появляются в виде фрагментов эритроцитов с острыми краями. Как и акантоциты, шизоциты наблюдают преимущественно при микроангиопатии (J.W. Harvey, 2000).
Эхиноциты
Эхиноциты — это шестерёнчатые (щетинистые) эритроциты с проецированием тонких и коротких острых кончиков одинаковой длины, распространяющихся одинаково по поверхности мембраны (фото 10). Обычно их присутствие является вторичным морфологическим артефактом, обусловленным избыточным введением ЭДТА и продолжительной экспозицией с момента забора крови до нанесения её на предметное стекло. Следовательно, присутствие эхиноцитов не является признаком какого-либо заболевания.
Так или иначе, число их может возрасти при определённых патологических состояниях, например в случае азотемии (J.W. Harvey, 2000).
| Фото 8. Считывание мазка крови под микроскопом у собаки (× 1000), подверженной гемангиосаркоме селезёнки. Отмечаются акантоциты (стрелки) | Фото 9. Считывание мазка крови под микроскопом (× 1000) у собаки, подверженной гемангиосаркоме селезёнки. Наличие кератоцитов (стрелка) |
| Фото 10. Считывание мазка крови под микроскопом (× 1000) у здоровой собаки. Эхиноциты, вероятно, носят вторичную природу вследствие артефакта во время приготовления мазка (стрелки) |
Полихроматофилы и условия их появления обусловлены регенеративной анемией.
В центре гипохромных зрелых эритроцитов имеется более выраженное просветление (бледность), потому что в отличие от нормы они располагают более низкой концентрацией гемоглобина (фото 11). Их присутствие ассоциируется в основном с железодефицитной анемией (например, при хронических наружных кровотечениях) (J.W. Harvey, 2000).
Нарушенные структуры и эритробласты
Нарушенные структуры. Тельца Гейнца и эксцентроциты
Тельца Гейнца (ТГ), как и эксцентроциты, образуются вследствие окислительного повреждения эритроцитов.
ТГ проявляются в виде розовой протуберанции (выступа) или бледного включения возле мембраны (фото 12). Эксцентроциты — это эритроциты уродливой формы с наличием светлой «растущей» структуры, находящейся сбоку мембраны (фото 13).
У собаки и кошки причина анемии с присутствием ТГ и эксцентроцитов имеет алиментарную природу (например, при поедании лука), а также медикаментозную (парацетамол и т. д.) или токсическую (цинк и т. д.) (M. Desnoyers, 2000; J.W. Harvey, 2000). У здоровой кошки редко встречаются эритроциты, которые могут иметь ТГ (до 5%). Их число может возрасти у больной сахарным диабетом кошки, не страдающей анемией, гипотиреоидозом и лимфомой.
Тельца Говелла-Жолли
Тельца Говелла-Жолли — это фрагменты ядер, которые не элиминировались из эритроцитов, и встречаются при регенеративной анемии или в результате проведения спленэктомии. Их также наблюдают иногда в нормальном состоянии, в основном у кошек (J.W. Harvey, 2000).
| Фото 11. Считывание мазка крови под микроскопом (× 500) у собаки с хронической потерей крови через кишечник. Отмечается гипохромия (стрелки), носящая вторичную природу вследствие дефицита железа | Фото 12. Считывание мазка крови под микроскопом (× 1000) у кошки, подверженной интоксикации парацетамолом. Следует обратить внимание на тельца Гейнца |
| Фото 13. Считывание мазка крови под микроскопом (× 1000) у собаки, подверженной интоксикации луком. Наличие эксцентроцитов (стрелки) | Фото 14. Считывание мазка крови под микроскопом (× 1000) у собаки, подверженной анемии вследствие пироплазмоза. Наличие Babesia canis (стрелка) |
| Фото 15. Считывание мазка крови под микроскопом у кошки (× 1000), подверженной гемолитической анемии, вызванной Mycoplasma hoemofelis (стрелки) | Фото 16. Считывание мазка крови под микроскопом у собаки (× 1000), имеющей регенеративную анемию. Отмечается наличие телец Говелла-Жолли (голубая стрелка) и эритробластов (чёрная стрелка) |
Паразиты
В эритроцитах можно обнаружить персистенцию паразитов. Два встречаются часто: Babesia canis у собак и Mycoplasma haemofelis (старое название: Hemobartonella felis) у кошек (фото 14 и 15). Первый имеет форму груши, часто бывает парным и при окрашивании по Романовскому-Гимзе имеет цвет от прозрачного до бледно-голубого с красным пурпурным ядром. Второй, Mycoplasma haemofelis, прикрепляется к поверхности эритроцитов, окрашивается в темно-голубой цвет (окраска по Романовскому-Гимзе) и может иметь форму кокка, кольца или палочки.
Эритробласты
Эритробласты — это ядросодержащие эритроциты, в стадии неполной зрелости. В основном они высвобождаются из костного мозга при достаточно выраженной регенерации у анемичных животных. Их появление в кровеносном русле также может указывать на нарушение костного мозга или на патологию селезёнки (фото 16) (J.W. Harvey, 2000; N.C. Jan, 1993).
Исследование эритроцитов позволяет дать серьёзную информацию, которая необходима для постановки диагноза. Например, выявление гипохромной анемии, которая чаще всего развивается при дефиците железа, позволяет задуматься о хроническом наружном кровотечении. Наличие акантоцитов в системе гемоциркуляции указывает на механическое повреждение эритроцитов, ассоциируемое с гемангиосаркомой, а также почечной гипертензией и т. д. Таким же образом иногда может быть поставлен окончательный диагноз. Так, регенеративная анемия в сочетании со сфероцитозом и агглютинацией, позволяет установить иммунную гемолитическую анемию.
Основные положения
— Тест на солевой раствор позволяет дифференцировать агглютинацию от образования «монетных столбиков».
— Регенеративная анемия характеризуется присутствием множества полихроматофилов в мазке крови.
— Присутствие сфероцитов и агглютинация являются характерным признаком иммунной гемолитической анемии у собак.
— Присутствие эхиноцитов часто является артефактом при подготовке мазка.
СВМ № 5/2010
Пойкилоцитоз эритроцитов что это такое
Пойкилоцитоз — отклонение в составе в крови, при котором эритроциты деформируются и прекращают нормально функционировать. Эритроциты представляют собой красные кровяные клетки, которые содержат гемоглобин и переносят кислород по всему организму.
Оглавление:
Присутствие в крови патологических изменённых эритроцитов свидетельствует о наличии заболевания, чаще всего о прогрессирование анемии.
Анализ
Пойкилоцитоз в общем анализе крови проявляется наличием эритроцитов с патологической трансформацией. Насторожить должны три патологии, которые могут определить в лаборатории: гипохромия (низкое содержание гемоглобина в эритроцитах), анизоцитоз (изменение клеток крови в размерах) и пойкилоцитоз. Анизоцитоз включает в себя макроцитоз (увеличенные эритроциты) и микроцитоз. Эритроциты маленьких размеров и называются микроцитозом.
Если вы увидели в бланке анализа заключение «Пойкилоцитоз» обратитесь к врачу, чаще всего это отклонение вызывается анемией тяжёлой степени.
Степень проявления
В расшифровке биохимического анализа указывается количество повреждённых эритроцитов. От их количества зависит стадия заболевания (во врачебной практике выражается в плюсах):
- 1 стадия (+). Минимальный пойкилоцитоз, количество трансформированных эритроцитов составляет не более 25%.
- 2 стадия (++). Умеренное заболевание, содержание патологических эритроцитов составляет половину от общего количества.
- 3 стадия (+++). Сильно выраженное заболевание, количество повреждённых эритроцитов не более 75%.
- 4 стадия (++++). Ярко выраженный пойкилоцитоз, деформированы практические все эритроциты%.
Разновидности и формы
В различных патологиях организма, которые затрагивают изменение кровяного состава, эритроциты деформируются по-разному. Выделяют восемь типов трансформации, которые характеризуют разные заболевания:
- Дакриоциты. Клетки овальной формы с заострённых концом. Характерны для патологий костного мозга, и как следствие нехватки железа в организме (низкий уровень гемоглобина).
- Эллиптоциды. Вытянутые клетки с закруглёнными краями. Характеры для малокровия, анемии различных стадий.
- Акантоциты. Клетки с конусообразными отростками, расположены на значительном расстоянии друг от друга. Характеризуют патологии печени.
- Эхиноциты. Клетка круглой формы с различными отростками, похожими на шипы. Появляются при патологиях ЖКТ, почечной недостаточности.
- Кодоциты. Из-за скопления гемоглобина в центральной части клетки выглядят как круг с затемнением в центре. Присутствуют в организме при заболевании печени (гепатит) или отравлении тяжёлыми металлами.
- Дрепаноциты. Содержат гемоглобин S, имеют вытянутую дугообразную форму с заострёнными концами. Характерны для кислородного голодания.
- Микросфероциты. Круглые клетки небольшого размера. Наблюдаются о пациентов с анемией (средней или тяжёлой степени) и микроцитозом.
- Гидроциты. По форме напоминают вогнутую линзу. Проявляются у людей с наследственным фактором стоматоцитоза. По размеру превышают здоровые эритроциты на 30%.
- Пузырчатая клетка. На поверхности эритроцита образуется образование не ясной этимологии. Наблюдаются при тяжёлых формах анемии.
СПРАВКА! Здоровые эритроциты имеют круглую, немного вытянутую форму без остроконечных включений.
Причины
Патологическая деформация эритроцитов возникает на фоне следующих заболеваний:
- Патологии печени: гепатиты различной этимологии, циррозы, онкологические новообразования.
- Анемия тяжёлой степени — самая распространённая причина пойкилоцитоза, анизоцитоза и гипохромии.
- Поражение костного мозга онкологическими заболеваниями (метастазами).
- Лимфома, фиброз.
- Уриния.
- Дефицит пируваткиназы.
- Нехватка витамина В12.
- Переливание крови.
СПРАВКА! Анемию тяжёлой степени, при ярко выраженном изменении клеток крови (пойкилоцитоз, анизоцитоз, гипохромия) лечится только под наблюдением врача.
У детей и грудничков
Наличие трансформированных эритроцитов в крови у детей в первые дни жизни является нормальным физиологическим явлением. Если ребёнок подрастает до 1 года и эритроциты не принимают здоровую форму, можно говорить об анемии. В раннем возрасте это заболевание может быть вызвано несовместимостью крови у матери и ребёнка (различие резус-фактора или группы крови). Если клетки гемоглобина имеют форму буквы S, то пойкилоцитоз вызван серповидноклеточной анемией (вызывает тромбозы сосудов и кровоизлияния), что является опасным состоянием для ребёнка. При любых отклонениях в составе крови важно как можно раньше обратиться к врачу для нормализации уровня гемоглобина в крови и восстановления функций кроветворения.
Лечение
Лечение назначается после полной диагностики организма. По одной форме эритроцитов нельзя судить о заболевании, можно только предположить его наличие.
- Если пойкилоцитоз вызван низким уровнем гемоглобина, назначается лечение, направленное на устранение железодефицита в организме. Рекомендуется включить в свой рацион продукты с высоким содержанием железа: мясо, морепродукты, фрукты, овощи. Если диета не приводит к положительной динамике, применяют лечение железосодержащими препаратами: «Сорбифер Дурулес» и другие.
- Если помимо пойкилоцитоза наблюдается гипохромия и анизоцитоз, проводится полная диагностика костного мозга и назначается лечение серьёзными медикаментами в стационаре.
- Заболевания печени можно выявить только путём дополнительной диагностики (печёночные пробы, УЗИ). Лечение должен назначать только врач, так как осложнения при патологиях печени очень опасны.
- Лечение анемии у новорождённых должно включать грудное вскармливание. Отлучать ребёнка, больного анемией, от груди раньше одного года ребёнка не рекомендуется, так как с материнским молоком младенец получает все необходимые витамины и микроэлементы для нормального кроветворения.
Профилактика
В целях профилактики необходимо следить за своим здоровьем и прислушиваться к симптомам. Здоровый образ жизни включается в себя правильное питание, активные физические нагрузки, здоровый сон, чистый воздух (без вредных газов и химикатов, которые активно оседают на печени). Рацион должен быть богат различными витаминами: овощи, фрукты, рыба, нежирное мясо — всё это считается составляющими правильного питания. Для поднятия уровня гемоглобина в крови рекомендуется пропить курс фолиевой кислоты, она содержится в листьях шпината, животной печени, дрожжах. Для того, чтобы не запустить пойкилоцитоз, старайтесь раз в год сдавать биохимический анализ крови, заболевания печени и кровеносной системы гораздо лучше поддаются лечению на ранней стадии.
Добавить комментарий Отменить ответ
При использовании данного сайта, вы подтверждаете свое согласие на использование файлов cookie в соответствии с настоящим уведомлением в отношении данного типа файлов. Если вы не согласны с тем, чтобы мы использовали данный тип файлов, то вы должны соответствующим образом установить настройки вашего браузера или не использовать сайт.
Источник: https://1pokrovi.ru/zabolevaniya/pojkilocitoz.html
Пойкилоцитоз
Пойкилоцитоз
Пойкилоцитоз — изменение формы эритроцитов, наблюдающееся при анемии и являющееся неблагоприятным прогностическим признаком.
Содержание
Анормальные формы эритроцитов
В норме форма эритроцитов является округлой или слегка овальной.
Сфероциты
- Сфероциты — эритроциты, потерявшие свою двояковогнутую форму и имеющие шаровидный вид. Эритроциты имеют значительную толщину и утрачивают центральное просветление.
Сфероциты имеют как обычные размеры, так и более мелкие (микросфероциты) с диаметром которых 4 — 6 мкм. Аномалия мембран эритроцитов этого вида склонны к гемолизу (наследственному или приобретенному).
Сфероцитоз наблюдается при следующих болезнях: анемии, септицемии, несовместимости крови по системе АВ0, синдроме ДВС, при имплантации искусственных сосудов, клапанов сердца, ожогах, аутоимунной болезни. Микросфероцитоз является патогномоничным признаком для анемии Миньковского-Шоффара (наследственный микросфероцитоз). Микросфероциты также встречаются в ряде других гемолитических анемий.
Эллиптоциты
- Эллиптоцит (овалоцит) — эритроциты овальной или удлиненной формы. Бледность в центре не видна. Аномалии мембраны или гемоглобина приводят к изменению формы клетки.
Встречаются при наследственном овалоцитозе (может быть в виде конституциональной аномалии или анемии), талассемии, мегалобластной анемии, железодефицитных анемиях, при циррозах печени, анемиях, связанных с дефицитом Г-6-ФДГ, глютатиона, серповидно-клеточной анемии. Может встречаться как артефакт (в толстом месте препарата).
Акантоциты
- Акантоцит (листообразная клетка, шпорообразная клетка): на поверхности эритроцитов наблюдаются выпячивания на разных расстояниях друг от друга.
Акантоциты наблюдаются при абеталипопротеинемии, тяжелых заболеваниях печени (токсический гепатит, цирроз, алкогольное поражение печени), наследственном дефиците пируваткиназы, наследственном сфероцитозе (тяжелые формы), при нарушении обмена липидов, гепаринотерапии.
Незначительное число акантоцитов можно встретить у пациентов после удаления селезёнки.
Кодоциты
- Кодоциты (мишеневидные эритроциты, лептоциты, таргетные клетки, колоколоподобные клетки): эритроциты плоские и бледные. Периферия эритроцитов окрашена, а гемоглобина сконцентрирован в центре клетки. Площадь кодоцитов увеличена за счет избытка холестерина.
Кодоциты выявляются при талассемиях, гемоглобинопатиях S, C, D и E, железодефицитной анемии, отравлении свинцом, болезнях печени, особенно сопровождающихся механической желтухой, после спленэктомии.
Дрепаноциты
- Дрепаноциты (серповидные клетки) — эритроциты либо серповидноклеточные, либо имеющие сходство с листьями остролиста.
Наблюдаются в случае серповидноклеточной анемии и ряде других других гемоглобинопатий. В дрепаноцитах находится гемоглобин-S, склонный к полимеризации. Такой вид гемоглобина деформирует мембрану, особенно при низкой его концентрации в крови.
Стоматоциты
- Стоматоциты — эритроциты, у которых центральное просветление имеет не округлую, а линейную форму, что напоминает ротовое отверстие. При суспендировании в плазме клетки приобретают форму чаши. Эти клетки имеют увеличенный на 20 — 30 % объем и площадь поверхности. Стоматоциты наблюдаются при наследственных сфероцитозе и стоматоцитозе, опухолях, алкоголизме, циррозе и обструктивных заболеваниях печени, кардиоваскулярной патологии, после трансфузий. Образуются при приеме некоторых лекарств.
Возможно выявление стоматоцитов, как артефактов.
Эхиноциты
- Эхиноцит (шишковидная клетка, ягодоподобная клетка, зубчатая клетка) — клетка, напоминающая по форме морского ежа, имеет шипы одинаковых размеров, располагающиеся равномерно по поверхности эритроцита.
Эхиноциты наблюдают при уремии, трансфузии крови, содержащей старые эритроциты, раке желудка, пептической язве, осложненной кровотечением, гипофосфатемии, гипомагниемии, при наследственном дефиците пируваткиназы, фосфоглицераткиназы. Часто встречается как артефакт.
Дегмациты
- Дегмацит («надкусанная клетка») — клетка выглядит так, как будто ее надкусили.
Дегмациты встречаются при недостаточности Г-6-ФДГ и нестабильности гемоглобина.
Пузырчатая клетка
- Пузырчатая клетка — эритроциты имеют на своей поверхности имеется пузырек или волдырь. Наблюдаются при иммунной гемолитической анемии.
Механизм образования пузырчатых клеток не вполне ясен.
Шистоциты
- Шистоциты (шизоцит, каскообразная клетка, фрагментированная клетка) — эритроциты формой похожи на каски, треуголки, осколки.
Шистоциты наблюдаются при микроангиопатии, гемолитической анемии (при действии физических факторов), злокачественной гипертонии, уремии, а также в случае осложнений при протезировании сосудов и клапанов, ДВС (сепсис, опухоль), при действии ряда лекарств и токсинов.
Дакриоциты
- Дакриоциты (слезоподобные клетки) — клетки имеют вид капель или головастиков.
Дакриоциты обнаруживают при миелофиброзе, миелоидной метаплазии, анемии при миелофтизе (ослабление или нарушение функции костного мозга при росте опухоли, гранулеме, лимфоме и фиброзе), талассемии, тяжелом дефиците железа, токсическом гепатите.
Ссылки
Wikimedia Foundation . 2010 .
Смотреть что такое «Пойкилоцитоз» в других словарях:
пойкилоцитоз — пойкилоцитоз … Орфографический словарь-справочник
пойкилоцитоз — Способность клеток одной ткани изменять форму: например, эритроциты (в норме эллипсоидные) могут иметь булавовидную, грушевидную и иную форму. [Арефьев В.А., Лисовенко Л.А. Англо русский толковый словарь генетических терминовс.] Тематики … Справочник технического переводчика
пойкилоцитоз — poikilocytosis пойкилоцитоз. Способность клеток одной ткани изменять форму: например, эритроциты (в норме эллипсоидные) могут иметь булавовидную, грушевидную и иную форму. (Источник: «Англо русский толковый словарь генетических терминов». Арефьев … Молекулярная биология и генетика. Толковый словарь.
ПОЙКИЛОЦИТОЗ — (poikilocytosis) наличие в крови эритроцитов разной необычной формы (пойкилоцитов). Особенно сильно пойкилоцитоз проявляется при миелофиброзе; также он может в той или иной степени наблюдаться практически при любом заболевании крови … Толковый словарь по медицине
пойкилоцитоз — (poikilocytosis; пойкилоцит + оз) наличие в периферической крови пойкилоцитов … Большой медицинский словарь
пойкилоцитоз — пойкилоцит оз, а … Русский орфографический словарь
Пойкилоцитоз (Poikilocytosis) — наличие в крови эритроцитов разной необычной формы (пойкилоцитов). Особенно сильно пойкилоцитоз проявляется при миелофиброзе; также он может в той или иной степени наблюдаться практически при любом заболевании крови. Источник: Медицинский словарь … Медицинские термины
АНЕМИЯ — АНЕМИЯ. Содержание: I. Местное малокровие. 702 II. Общее малокровие: Острая анемия. 704 Хроническая анемия. 705 III. Анемия злокачественная. 708 ІV. Хлороз. 715 V. Анемия в детском… … Большая медицинская энциклопедия
Железодефицитная анемия — Эту статью следует викифицировать. Пожалуйста, оформите её согласно правилам оформления статей. Железодефицитная анемия … Википедия
АКТИНОМИКОЗ — АКТИНОМИКОЗ, actinomycosis (от греч. aktis луч и mykes гриб), лучисто грибковая болезнь, вызываемая внедрением в человеческий или животный организм ак тиномицетов (Actinomycetes), лучистых грибков. Актиномицеты группа низших растительных… … Большая медицинская энциклопедия
Поделиться ссылкой на выделенное
Прямая ссылка:
Мы используем куки для наилучшего представления нашего сайта. Продолжая использовать данный сайт, вы соглашаетесь с этим. Хорошо
Источник: https://dic.academic.ru/dic.nsf/ruwiki/
Пойкилоцитоз в анализе крови: что это такое и как с этим бороться?
Кровь как система организма отвечает за большое количество важнейших для жизни функций. Их выполнение становится возможным за счёт наличия в составе жидкой ткани (крови) определённых клеток: эритроцитов, лейкоцитов и тромбоцитов. Различные внешние и внутренние факторы могут оказывать негативное воздействие даже на эти элементы, угнетая основные функции кровяных клеток и ухудшая состояние организма. Одно из таких состояний — пойкилоцитоз — наблюдается при тяжёлых заболеваниях и значительно ухудшает процессы перемещения кислорода к тканям.
Пойкилоцитоз: что означает такой результат анализа крови?
Эритроциты в здоровом виде имеют форму вогнутого с двух сторон диска, в такой клетке нет ядра, а основная масса цитоплазмы (наполнения клетки) представлена белком — гемоглобином. Именно эритроциты в здоровом виде отвечают за транспортировку кислорода ко всем тканям организма человека. По результатам анализа крови может быть поставлен диагноз пойкилоцитоз — это состояние, которое подразумевает изменение формы эритроцитов разной степени тяжести, из-за чего они уже не способны выполнять свою задачу в системе.
Поставленный диагноз говорит о наличии довольно серьёзной анемии у пациента — среднетяжелого и тяжёлого течения. В зависимости от того, какую долю составляют трансформированные (изменённые) клетки в общей формуле, и определяется серьёзность ситуации:
- «+» — четверть от всего количества эритроцитов изменена, проблема признаётся несущественной;
- «++» — средняя степень выраженности пойкилоцитоза, когда изменения затронули половину клеток;
- «+++» — выраженная форма состояния, свой вид и функцию сохранила только четверть эритроцитов, все остальные — изменены;
- «++++» — самая тяжёлая, острая форма, при которой полностью все клетки, переносящие кислород, деформированы.
Проблему, спровоцировавшую такое состояние кровяной формулы, часто выявляют на основании характера изменения формы клетки. Так, можно говорить о таких разновидностях пойкилоцитоза:
- эритроциты по форме похожи на капли — дакриоциты;
- акантоцитами называют клетки, которые имеют по краям отростки в виде шипов;
- клетки серповидной формы называются дрепаноцитами;
- кодоциты — эритроциты, которые насыщены холестерином и внешне похожи на мишень;
- стоматоциты в отличие от нормальной формы эритроцитов вогнутые только с одной стороны, а со второй — выпуклые;
- шарообразные клетки с многочисленными отростками носят название эхиноциты;
- эллиптоциды — овальные кровяные клетки, которые могут присутствовать и у здорового человека, но их количество не должно превышать десятой части. В противном случае говорят о наличии проблемы со здоровьем;
- клетки-осколки — шистоциты;
- дегмацит визуально напоминает обычную клетку, которую немного «надкусили».
Замечание специалиста: выделяют ещё больше разновидностей деформаций, постоянно добавляются новые варианты, и каждый из них связан с определённым патологическим процессом в человеческом организме, что позволяет эффективно сужать круг причин и наиболее быстро выявлять истинную.
Причины и признаки деформации
Существует множество состояний, способных проявляться в формуле крови деформациями эритроцитов или разновидностью пойкилоцитоза, а основные симптоматические проявления по большей части зависят от источника проблемы и степени тяжести изменения кровяной формулы.
Итак, деформации эритроцитов наблюдаются у пациентов с острым дефицитом железа, который провоцирует снижение показателей гемоглобина. Такая зависимость имеет место в 80% всех случаев обнаружения изменения в анализе. У остальных пациентов состояние провоцируется одним из таких факторов:
- токсический гепатит из-за чрезмерного употребления алкоголя;
- отравление свинцом;
- затянутая форма желтухи;
- нарушение работы почек и мочевыводящей системы в целом;
- проведение операции по имплантации сердечного клапана или искусственных сосудов;
- осложнение после кровотечения и т.д.
Как и у взрослых, основная причина пойкилоцитоза в детском возрасте, в частности у грудничка, — это анемия, но может иметь место ещё один аспект — вероятность врождённых нарушений в работе костного мозга, сосудов и т.д.
Очевидно, что специфических симптомов проблема не имеет, проявления изменений определяются тем, какая именно причина их спровоцировала. Так, при наличии анемии пациентов беспокоит:
- сильная слабость в теле;
- побледнение кожных покровов;
- частые головокружения и приступы тошноты;
- на фоне слабости иногда случаются обмороки.
Опасность состояния
Как известно, изменение формы эритроцитов ведёт к снижению гемоглобина в крови и нарушению нормального функционирования этих кровяных клеток. Из-за пойкилоцитоза нарушается процесс транспорта кислорода к клеткам, следовательно, изменения возникают и в протекании метаболизма, ткани начинают испытывать острую нехватку кислорода, что очень опасно. Такое положение вещей заставляет организм активизировать механизмы приспособления, из-за которых у пациента и возникают жалобы: сердцебиение чётко ощущается, иногда возникают сердечные боли, дыхание учащается, постоянно преследует одышка.
Длительный острый пойкилоцитоз ведёт к изменениям в тканях важнейших органов, начинаются деструктивные процессы, которые без соответствующих мер значительно сокращают длительность жизни.
Лечение недуга у детей и взрослых
Для устранения пойкилоцитоза первое, что нужно сделать — это нейтрализовать причину такого состояния, скорее всего, анемию.
Для ускорения и облегчения процесса восстановления клеток крови можно пользоваться простыми советами по увеличению показателей гемоглобина. Нужно употреблять больше продуктов, богатых железом — любое мясо, желательно не очень жирное, хороший эффект даёт говяжья печень и отварной язык. Обязательным является наличие в рационе продуктов, насыщенных витамином С (цитрусовые, гранат), полезными окажутся соки из морковки, свёклы и граната.
Медикаментозная терапия сводится к назначению препаратов железа для устранения признаков анемии. Если патология вызвана недостатком витамина В12, препарат вводится внутривенно по назначению врача.
Фотогалерея: продукты для устранения пойкилоцитоза
Состояние пойкилоцитоза — это изменение формы и, соответственно, нарушение функции эритроцитов крови. Без соответствующего лечения наступает ряд деструктивных изменений в важнейших органах, поэтому важно вовремя среагировать на проблему и незамедлительно обратиться к врачу при характерных недомоганиях.
- Автор: Елена Гостищева
- Распечатать
Материал публикуется исключительно в ознакомительных целях и ни при каких обстоятельствах не может считаться заменой медицинской консультации со специалистом в лечебном учреждении. За результаты использования размещённой информации администрация сайта ответственности не несёт. По вопросам диагностики и лечения, а также назначения медицинских препаратов и определения схемы их приёма рекомендуем обращаться к врачу.
Источник: https://krasnayakrov.ru/analizy-krovi/poykilotsitoz-v-analize-krovi-chto-eto-takoe.html
Пойкилоцитоз эритроцитов: понятие, степени, виды и причины
пойкилоцитоз в крови
От незначительного до выраженного – цифры, слова и плюсики
- Незначительный пойкилоцитоз — присутствие в мазке от 25 до 50% красных клеток крови, которые отличаются от нормальных по форме, или 1, или +;
- Умеренный пойкилоцитоз — от 50 до 70% клеток отличаются от нормальных эритроцитов по форме или 2, или ++;
- Выраженный пойкилоцитоз — от 70 до 75% эритроцитов имеют отличия по форме или 3, или +++;
- Резко выраженный пойкилоцитоз — до 100% кровяных телец не укладываются по форме в характеристики нормальных эритроцитов, 4 или ++++.
Двояковогнутая форма – зачем она нужна красным клеткам?
Варианты изменения формы эритроцитов
- Анулоциты – напоминающие пустые колечки образования, непохожие на настоящие красные клетки крови, нередко отмечаются при выраженном дефиците железа в организме;
- Сфероциты – эти клетки отличает шаровидная форма и уменьшенный размер (d ≈ 4 – 6 микрон), срединное просветление у них не просматривается. Такие эритроциты появляются при различных патологических состояниях (гемолитическая анемия Минковского-Шоффара – наследственный микросфероцитоз, анемический синдром, ставший следствием обширных ожогов, АВ0-несовместимые гемотрансфузии, ДВС-синдром, искусственные сердечные клапаны и пр.);
- Овалоциты, их еще по-другому называют эллиптоцитами – клетки имеют характерную форму эллипса, присутствуют у здоровых людей в количестве, не превышающем 10%, значительно «размножаются» при наследственном овалоцитозе, некоторых талассемиях и анемическом синдроме, обусловленном лейкозом;
- Планоциты или лептоциты– уплощенные или вовсе плоские клетки, характерны для железодефицитной анемии, отдельных гемоглобинопатий;
- Мишеневидные эритроциты (кодоциты) — из-за скопления красного пигмента крови по центру клетки наблюдается образование, напоминающее мишень. Подобного рода клетки свойственны для ЖДА, ДВС-синдрома, хронической алкогольной интоксикации и многих гемоглобинопатий (талассемий);
- Дакриоциты – слезовидные клетки-капельки, появляющиеся в мазке вследствие серьезных поражений паренхимы печени (токсический гепатит) или тяжелого железодефицитного состояния;
- Акантоциты отличаются зубчатой формой, характерны для наследственного акантоза, печеночной патологии, гемолитической анемии, алкоголизма и состояний после удаления селезенки;
пример пойкилоцитоза с акантоцитами
- Шизоциты (мелкие) и кератоциты (более крупные, шлемовидные) – не клетки вовсе, а их фрагменты, оставшиеся после распада эритроцитов. Фрагментированные эритроциты могут появляться в случае тяжелого течения анемии, при ДВС-синдроме, васкулитах, злокачественной гипертензии, после протезирования клапанов сердца, а также при гемолитико-уремическом синдроме;
- Эритроциты в форме серпа (серповидные кровяные тельца или, как их еще называют, дрепаноциты) являются характерным признаком серповидно-клеточной анемии, однако в обычном препарате обнаружить такие клетки не удается, даже если они массово «заселяют» мазок. Находят серповидные эритроциты путем создания искусственной гипоксии на стекле, в условиях которой они себя хорошо проявляют;
- Стоматоциты (или гидроциты) – названы так, поскольку срединное просветление в центре клетки имеет форму изогнутой линии, похожей на рот. Подобные эритроциты отмечаются после гемотрансфузий, при поражениях печени (цирроз) и алкогольной интоксикации. Стоматоцитами представлены «взрослые» клетки эритроидного ряда в случае дефекта структурных белков мембраны Er — наследственного стоматоцитоза, протекающего с анемией, распадом красных кровяных телец в селезенке и изменением их формы;
Причины появления пойкилоцитоза в общем анализе крови
- Дефицит в организме такого важного химического элемента, как железо (Fe) по причине его недостаточного поступления с пищей (диеты), нарушенного всасывания (патология желудка и кишечника), повышенной потребности (вынашивание ребенка, кормление грудью, возраст активного роста и развития). Для железодефицитных состояний, протекающих в тяжелой форме, анизопойкилоцитоз и гипохромия относятся к характерным признакам болезни;
- Витаминная недостаточность (в первую очередь, дефицит витаминов группы В — В12, В9 — фолиевая кислота);
- Наследственная патология (гемолитические анемии и другие болезни крови);
- Метастатическое поражение главного кроветворного органа – костного мозга, миелодиспластические синдромы (для данной патологии наиболее характерно появление в крови клеток, отличающихся между собой не только размерами, но и формой);
- Инфекционные заболевания, протекающие с тяжелой интоксикацией (транзиторное проявление пойкилоцитоза);
- Диффузные поражения печеночной ткани и паренхимы поджелудочной железы;
- Гемолитико-уремический синдром – тяжелая патология, обусловленная воздействием многих неблагоприятных факторов и проявляющаяся сочетанием гемолитической анемии и тромбоцитопении не иммунного характера с острой почечной недостаточностью (ОПН);
- Протезирование клапанов сердца;
- Состояния после гемотрансфузий, особенно, несовместимых по системе АВ0.
Источник: https://sosudinfo.ru/krov/pojkilocitoz/
Пойкилоцитоз в общем анализе крови
Кровь омывает все органы и ткани человеческого тела и несет ряд важнейших функций. Составляющие крови (лейкоциты, эритроциты, тромбоциты) естественным образом реагируют на изменения в состоянии здоровья человека. Для выявления подобных изменений проводят лабораторное исследование мазка крови. В некоторых случаях при оценке мазка обнаруживают пойкилоцитоз в анализе крови.
Что означает пойкилоцитоз
У здорового человека эритроциты в крови представлены безъядерным двояковогнутым диском. По центру клетки находится центральный просвет (светлая часть), а наружные края окрашиваются в более темный цвет. Цитоплазма зрелых эритроцитов заполнена дыхательным пигментом – гемоглобином. Он связывается с молекулами кислорода и переносит ее к клеткам всего организма, забирая обратно углекислый газ. Таким образом обеспечивается дыхательная функция крови. Красный цвет пигмента обуславливает цвет крови, сами же эритроциты зеленовато-желтые.
Фото изменения формы эритроцитов
Изменение формы эритроцитов называется пойкилоцитозом. Степень пойкилоцитоза оценивают следующим образом:
- «+» — 25% от общего количества подвергнуто изменениям. Такой результат принимается за норму эритроцитов.
- «++» — деформировано половину красных кровяных клеток, средняя степень пойкилоцитоза.
- «+++» — 75% эритроцитов изменено по форме, выраженная степень.
- «++++» — изменения формы затрагивают все видимые в поле зрения эритроциты. Острая форма пойкилоцитоза.
Эритроциты при пойкилоцитозе принимают различные формы в зависимости от причины деформации.
Классифицируют следующие разновидности пойкилоцитозных эритроцитов:
- дакриоциты – формой напоминают каплю или слезу, часто имеют уменьшенный размер и включения соединений гемоглобина в крови – тельца Гейнца;
- акантоциты имеют зубчатую поверхность и неравномерную окраску;
- клетки серповидной формы называются дрепаноцитами;
- кодоциты или мишеневидные клетки имеют увеличенную общую поверхность и повышение холестерина в цитоплазме;
- центральный просвет у стоматоцитов (гидроцитов) имеет щелевидную форму. Увеличенный объем клетки обуславливает ее короткий срок жизни в микроциркуляторном русле;
- эхноциты вследствие нарушений клеточной мембраны имеют сферическую форму сотростками (репеевидная форма);
- эллиптоциты в норме не должны превышать 1% от всех эритроцитов; Красные кровяные тельца имеют овальную форму и разные размеры;
- шистоциты – это фрагментированные, частично разрушенные клетки крови;
- дегмациты имеют полукруглую форму с отсутствием одного края;
- полукруглые клетки с вытянутой у одного края цитоплазмой и скоплением гемоглобина у другого края называются эсентроциты.
Классификация морфологических изменений эритроцитов очень обширна и постоянно пополняется новыми видами специфических деформаций.
Разновидности пойкилоцитозных эритроцитов
Причины и признаки деформации
Важно понимать, что пойкилоцитоз в анализе крови сам по себе не является диагнозом. Это – последствие нарушений здоровья, в первую очередь различных видов анемии, болезней печени и обмена веществ.
Не существует четкой причины между характером деформации и определенной болезнью пойкилоцитоза. Классификация измененных эритроцитов указывает на целый ряд признаков и заболеваний, вызвавших пойкилоцитоз. С определенностью можно выделить лишь дрепаноциты. Их появление – свидетельство серповидноклеточной анемии. Дрепаноциты наполнены измененной формой гемоглобина (Hb S), который специфически деформирует клеточную мембрану, особо при дефиците кислорода.
Для подтверждения дрепаноцитоза используют «пробу жгута» – палец туго бинтуют, чтобы искусственно вызвать недостаток кислорода. После проводят забор крови из пальца. Выявленные в обилии дрепаноциты подтверждают диагноз.
Появление в мазке крови эхиноцитов может говорить о патологическом избытке в крови продуктов обмена веществ (уремии) или наследственном дефиците определенных групп ферментов.
При вышеуказанных состояниях, а также железодефицитной анемии, болезнях печени в крови появляются и акантоциты. Длительная механическая и обструктивная желтуха, отравление свинцом, удаление селезенки провоцируют преобладание мишеневидных эритроцитов.
При миелофиброзе, болезнях костного мозга, увеличении селезенки в мазке крови будут превалировать дакриоциты. Причем содержание клеток разных размеров повышается при железодефицитной анемии. Одинаковые же по размеру эллиптоциты свидетельствуют о наследственных болезнях крови. На гемолитическую анемию, спровоцированную приемом лекарственных средств, указывают шистоциты и дегмациты.
Виды деформации клеток
Опасность состояния
Жизненный цикл здорового эритроцита составляет 120 дней – с момента выхода из красного костного мозга до гибели в селезенке. Изменение формы эритроцитов зачастую обуславливается изменениями его клеточной мембраны, нагромождением вредных балластных веществ внутри клетки и нарушениями функции дыхательного пигмента – гемоглобина. Деформированные клетки хуже связывают кислород, быстрее «изнашиваются» и гибнут. Видоизмененные эритроциты теряют свою эластичность, что мешает им участвовать в микроциркуляции – снабжать кислородом и выводить углекислый газ из отдаленных участков тела.
Чтобы восполнить природную необходимость клеток организма в кислороде включаются компенсаторные механизмы. Дополнительный приток кислорода обеспечивается за счет учащенного дыхания и сердцебиения – отсюда одышка при сердечной недостаточности, боли в сердце, бледность и цианоз (посинение) кожи, головокружения и обморочные состояния. Однако такие механизмы компенсации не способны в полной мере восполнить дефицит кислорода, питание тканей ухудшается, изменения здоровья нарастают и требуют медицинского вмешательства.
Лечение
Чтобы вылечить пойкилоцитоз, в анализе крови необходимо четко установить причину патологического состояния. Хорошо будет проконсультироваться у опытного врача-гематолога. Часто врачи назначают для лечения у детей и взрослых, препараты железа, витамина B 12 для длительного употребления.
Полезные продукты питания
Самостоятельно можно провести коррекцию питания и ввести в рацион полезные продукты. Для обогащения крови гемоглобином в пищу употребляют отварное мясо нежирных сортов, говяжью печень, язык, ветчину. Пища должна быть богата витаминными веществами и кальцием, поэтому необходимы сыр, творог, цитрусовые, свекла, морковь, сладкий перец, квашеная капуста, бобовые. Жиры в питании ограничиваются. В качестве напитка можно использовать отвар шиповника, гранатовый сок, ягодные морсы.
Для ребенка грудного возраста, важно как можно дольше сохранять грудное вскармливание.
Поскольку пойкицитоз – последствие тяжелых нарушений здоровья, его легче предотвратить, чем устранять. Лучшая профилактика – рациональное питание и активный образ жизни.
Видео — Форменные элементы крови, эритроциты:
Похожие записи:
Есть вопросы? Задайте их нам Вконтакте
Поделитесь своим опытом в данном вопросе Отменить ответ
Внимание. Наш сайт носит исключительно информационный характер. Для более точной информации, определения вашего диагноза и способа его лечения — обратитесь в клинику на прием к врачу за консультацией. Копирование материалов на сайте разрешено только с размещением активной ссылки на первоисточник. Прочтите пожалуйста сначала Соглашение об использовании сайта.
Если Вы нашли ошибку в тексте выделите ее и нажмите Shift + Enter или нажмите здесь и мы постараемся быстро исправить ошибку.
Спасибо за Ваше сообщение. В ближайшее время мы исправим ошибку.
Рубрикатор
Подписаться на рассылку
Подпишитесь на наши новости
Источник: https://sostavkrovi.ru/analizy/obshchiy/poykilotsitoz-v-obshchem-analize-krovi.html
Пойкилоцитоз в общем анализе крови: причины возникновения, что это такое
В медицине нередки случаи, когда общий анализ крови выявляет патологию со стороны отдельных форменных элементов сыворотки — эритроцитов. Он могут изменяться в размерах, деформироваться и за счет этого перестают правильно функционировать. Такое отклонение называется пойкилоцитозом.
Обнаруженный пойкилоцитоз в общем анализе крови свидетельствует о начинающейся или уже прогрессирующей анемии. Все, что связано с изменением эритроцитов, безусловно, волнует пациентов. Мы попробуем выяснить причины данного явления и ответим на вопрос, стоит ли паниковать, получив на руки неидеальные результаты исследования.
Что нужно знать о пойкилоцитозе
Итак, вы сдали кровь, а в ней обнаружен пойкилоцитоз. Естественно, сразу же возникает вопрос у простого несведущего обывателя: а что это вообще такое, этот самый пойкилоцитоз.
Начнем с самого начала. Природа всегда все продумывает до мелочей. Не обошло это правило и строение эритроцитов — кровяных телец, которых в нашей кровяной жидкости больше всего. Они прекрасно справляются с функцией транспортировки кислорода к тканям и органам. В этом им помогает их форма в виде диска, вогнутого с двух сторон, и содержание гемоглобина в нем.
Выполнять свое дело на «отлично» могут только здоровые клетки. А теперь представьте, что под влиянием негативных факторов, прогрессирующего заболевания или начинающегося недуга эритроцит начинает деформироваться, меняет свои размеры и форму. Разве может «поломанная» клетка выполнять свои функции как прежде? Конечно, нет. Тогда она пытается подать сигналы помощи через кровь.
Обнаружить любую патология несложно. Достаточно сдать общий анализ крови и дождаться результатов. Если в крови выявлены признаки патологии эритроцитов, это может быть как симптомом анизоцитоза, так и пойкилоцитоза, следует немедленно обратиться к врачу.
Не стоит путать или объединять воедино два разных медицинских явления. Анизоцитоз — показатель начальной стадии анемии, при которой изменяются размеры эритроцита. Пойкилоцитоз — явление более серьезное, говорящее об анемии в стадии быстрого прогрессирования из-за изменения формы кровяного элемента.
О тяжести патологии свидетельствует уровень видоизменения внешнего вида эритроцита. Всего их 4:
Причины пойкилоцитоза
Пойкилоцитоз в анализе крови может быть вызван различными заболеваниями, которые провоцируют деформацию красных телец.
Настороженность должны вызывать не только деформированные клетки, но их количество. Анизоцитоз часто становится следствием начавшейся анемии или других патологических процессов, которые точно сможет назвать только врач.
Причины, которые вызвали изменения кровяных компонентов, определяют по форме и степени деформации эритроцитов.
- Заболевания печени
- Анемия гемолитического типа
- Дефицит такого компонента как пируваткиназа
- Патологическая нехватка железа в организме
- Токсический гепатит по причине хронического алкоголизма
- Недостаток кислорода во всей кровеносной системе
- Долговременная желтуха
- Отравление свинцом
- Удаление селезенки
- Алкоголизм
- Желчекаменная болезнь
- Раковые опухоли в печени
- Гемолитическая анемия, вызванная сепсисом, ожогами, установкой на сердце искусственных клапанов
- Свойственны людям с наследственным стоматоцитозом
- Недостаток витамина А
В редких случаях алкогольный цирроз печени либо онкология
- Анемия
- Повышенный уровень эллиптоцитов определён наследственностью
- Лейкоз
- Тяжелые почечные заболевания
- Повышенная кислотность
- Рак желудка
- Вследствие большой кровопотери
Только тщательно проанализировав видоизменение эритроцитов, врач может оценить степень серьезности недуга и назначит своевременную терапию.
Среди форм пойкилоцитоза есть те, которые достаточно легко корректируются, такие, как эхиноциты или стоматоциты. Но есть и те, которые ведут за собой необратимые процессы в организме.
«Спутница» пойкилоцитоза
При воздействии каких-либо факторов эритроциты могут не только деформироваться или увеличиваться в размерах, но и менять свою окраску: красными они остаются только по краям, а внутри становятся светлыми. Это гипохромия — патология красных клеток, связанная с низким уровнем гемоглобина в эритроците. В результате этойаномалии эритроциты и превращаются в те самые кодоциты, или «мишеневидные» тельца.
Гипохромия ведет за собой гипохромную анемию. Этот вид анемии включает в себя все разновидности малокровия, которые вызваны цветовым изменением эритроцитов: железодефицитная анемия, анемия смешанного типа, низкий гемоглобин в связи с перераспределением железа. Для всех них характерны одни и те же симптомы: слабость, вялость, бледность, учащенное сердцебиение, апатия, раздражительность.
При появлении хотя бы пары симптомов рекомендуется сделать общий анализ крови.
О правильном лечении и профилактике
Выяснив, что такое пойкилоцитоз, нужно понять, как его лечить, а еще лучше — не допустить.
Деформация эритроцитов — это не болезнь, а симптом. Чаще всего за ним скрывается анемия. Поэтому все лечение направляется на устранение именно этой болезни.
Для нашей страны самым частым видом малокровия является анемия, вызванная недостатком или дефицитом железа. Врач назначит железосодержащие препараты, которые приведут уровень гемоглобина к нужному уровню. Если же анемия вызвана дефицитом витамина В12, то, скорее всего, будут назначены капельницы с этим самым витамином.
Помните, что самолечение при анемии недопустимо. Только после прохождения лабораторного исследования и точного определения типа анемии врачом будет индивидуально подобрано лечение.
Большую роль в повышении гемоглобина играют продукты питания. В качестве профилактики анемии или ее лечения рекомендуется употребление следующих продуктов:
Испокон веков считалось, что яблоки — бесценный источник железа. Оказалось, что это не так. Но для поддержания витаминного комплекса в своем организме, кушайте яблоки себе на здоровье.
Главной профилактической мерой появления пойкилоцитоза в крови является своевременная и систематическая сдача крови для клинического анализа.
Источник: https://pro-analiz.ru/krov/pojkilotsitoz-v-obshhem-analize-krovi.html
Причины появления пойкилоцитоза в общем анализе крови
Что означает пойкилоцитоз в общем анализе крови, причины, вызывающие его появление — эти вопросы интересуют многих пациентов. Эритроциты — это красные кровяные тельца, которые снабжают ткани и органы кислородом, они содержат гемоглобин. В нормальном состоянии они имеют форму двояковогнутых дисков, ядро в них отсутствует. Такая форма является оптимальной, поскольку обеспечивает газообмен.
У здорового человека содержится 4,0-5,0*10 12 г/л у мужчины, и 3,7-4,7*г/л у женщины. Если количество их больше нормы, то врач делает предположение, что у пациента начинает развиваться лейкоз. Причин повышения их в крови может быть несколько. Однако нередко врачи обнаруживают пойкилоцитоз в общем анализе крови. Компенсаторный эритроцитоз нередко встречается у совершенно здоровых людей, но может быть и проявлением серьезного заболевания.
Почему происходит изменение формы эритроцитов
Иногда в анализе крови отмечается изменение формы эритроцитов, врачи называют это состояние пойкилоцитозом, которое чаще всего возникает на фоне анемии.
Не все эритроциты в крови имеют правильные контуры, но если их слишком много, то это может вызвать настороженность.
Далеко не всегда изменение их формы связано с патологией, за исключением микросфероцитов, которые наблюдаются при синдроме Минковского -Шоффара, и эритроцитов серповидной формы.
Некоторые формы пойкилоцитоза считаются обратимыми. К ним относятся эхиноциты и стоматоциты, однако остальные формы патологии считаются необратимыми.
Эхиноциты — это разновидность сферических клеток, на поверхности которых находятся от 30 до 50 спикул. Если патология находится на стадии дискоцит-эхиноцит, то она может быть обратимой. Одной из причин образования этих клеток является высокая кислотность организма.
Акантоциты — эти эритроциты нередко приобретают форму с зубчиками, с булавовидными расширениями. Спикулы имеют разную длину и толщину.
Причиной этой патологии являются:
- заболевания печени,
- тяжелые формы анемии гемолитического типа,
- абетолипопротеинемия наследственного происхождения,
- дефицит пируваткиназы.
Стоматоциты — эти клетки имеют увеличенный объем, площадь их составляет 20-30%. Форма стоматоцитов — щелевидная с увеличением центрального просвета. Причин образования данной патологии несколько: это может быть низкая кислотность, недостаток витамина А при стомацитозе. Реже они образуются при заболеваниях печени обструктивного типа, при циррозе на фоне алкоголизма, при онкологии.
При серповидно-клеточной анемии образуются серповидные клетки. Характерно образование этих клеток и при других синдромах, например, если в крови не хватает кислорода.
В мишевидных клетках содержится повышенный холестерин, который приводит к тому, что эритроциты становятся больше по площади. Мишевидные клетки имеют окрашенную периферию, которая располагается на более светлой части. Образование кодоцитов характерно при заболеваниях печени и желтухе.
Слезовидные клетки имеют в своей структуре спикулу большого размера, нередко в них имеются тельца Гейнца. Образовываются они при фиброзах и при анемических состояниях, но реже.
Микросфероциты — это клетки, которые характерны для микросфероцитоза наследственного происхождения. Существует несколько видов этих клеток. Очень часто они образуются при термальных стадиях при необратимых процессах.
Эллиптоциты, как правило, не превышают более 1% в плазме крови. Анемические состояния приводят к увеличению их в несколько раз. Овалоциты могут быть неоднородны. Чаще всего образование происходит при наследственном эллиптоцитозе.
Чем опасно состояние пойкилоцитоза?
Эритроциты — очень важные элементы крови, которые обеспечивают организм кислородом, в их составе присутствует гемоглобин. Они переносят кислород по всему организму. Если происходит изменением формы, то это приводит к тому, что они уже не могут выполнять свои функции.
Чаще всего пойкилоцитоз развивается на фоне заболеваний кровеносной системы.
Чаще всего данная патология обнаруживается в обычном анализе крови. Если результат исследования выявил анизоцитоз или пойкилоцитоз, то нужно пройти обследование у врача. Возможно, все не так страшно, и у больного просто небольшая анемия, которая не представляет угрозы для жизни пациента, и поддается лечению.
Но нередко это может свидетельствовать о том, что в организме имеется серьезное заболевание. Количество видоизмененных клеток указывается с помощью плюсиков:
Изменения их очень часто свидетельствуют о наличии заболеваний. Они определяются в зависимости от патологии:
- Если в крови присутствуют акантоциты, которые характеризуются шпорообразной формой, то возможно, имеется абеталипопротеинемия или нейроаканцитоз.
- При хроническом алкоголизме, на фоне которого возникает токсический гепатит, часто образуются дакриоциты. Они также свидетельствуют о том, что в организме очень низкий гемоглобин.
- При недостатке кислорода в крови образуются серповидные клетки. Это происходит из-за того, что происходит деформация мембран.
- При желтухе или серьезных отравлениях образуются кодоциты. Они по форме похожи на мишень.
- При гемолитической анемии образуются микросфероциты. Они по форме похожи на шар и имеют большую толщину и небольшой диаметр.
- При развитии стомацитоза образуются стоматоциты.
- При тяжелых заболеваниях почек в плазме крови образуются эхиноциты, которые внешне похожи на шар.
При каких заболеваниях происходит разрушение эритроцитов
В том случае, если обнаруживается гипохромия, то это характерно для проявления железодефицитной анемии и онкологии желудка. Нередко обнаруживаются виды анемии, при которых происходит разрушение эритроцитов. При гемолитической анемии они разрушаются очень быстро. При апластической анемии нарушается процесс выработки красных клеток крови в костном мозге.
На фоне некоторых видов онкологии часто развивается эритроцитоз паранеопластического типа. Кроме того, изменение размеров эритроцитов бывает связано с:
Микроцитозом — они становятся очень маленькими. Это состояние связано с разными типами анемии и онкологией.
Макроцитозом — красные кровяные клетки имеют большой размер. Подобное состояние наблюдается при разных типах анемий (В12), при заболевании малярией, печени и легочных тканей.
Мегацитозе — размер превышает более 9,5 мкм. Характерен для В 12 анемии и в состоянии острого лейкоза.
Поликилоцитозом — изменение формы эритроцитов. Состояние характерно для В 12 анемии, а также некоторых других.
Таким образом, можно сделать вывод о том, что результаты анализов крови имеют большое значение для своевременного выявления и эффективного лечения различных заболеваний.
Копирование материалов сайта возможно без предварительного согласования в случае установки активной индексируемой ссылки на наш сайт.
Источник: https://tvoianalizy.ru/krovi/obshhij/pojkilocitoz-v-obshhem-analize-krovi-prichiny.html
Механизм формирования патологических мишеневидных эритроцитов в кровяной плазме
Мишеневидными эритроцитами называется вид патологической формы эритроцитов, обладающий плоскими очертаниями с низкой концентрацией гемоглобина, находящегося в центральной части клетки. Данный тип кровяных клеток появляется при талассемии. Отличается от здоровых форм уплотнением в центре, где скапливается гемоглобин. Гемоглобиновые клетки создают характерное в круге мишени пятно высокой насыщенности. Время от времени контрастное кольцо вступает в реакцию со сферой перемычки.
Как выглядят патологические формы?
Данное пятно смещается в шлемовидную форму, образующуюся по краям мембраны. Чтобы разобраться, как формируются мишеневидные эритроциты, можно в качестве примера зажать резиновый шар. Вмятины увеличиваются, пока не дотронуться до вершин, затем дно самой мягкой вмятины выпячивается, формируя выпуклость, где концентрируется избыточная поверхность. Из-за слабой устойчивости центральной выпуклости, спровоцированной лишней поверхностью, начинается формирование перемычек, шлемовидных холмиков и полос.
Характеристика морфологии мишеневидных клеток
В мишеневидном эритроците мало гемоглобина. В классификации нормальных эритроцитов должно быть 30 процентов гемоглобина от объема клетки. Нехватка вещества вызывает сокращение клеточного объема, формирование плоской формы.
Изменение формы эритроцитов приводит к тому, что они становятся жесткими, плоскими и тонкими. Диаметр клетки растет до 8,5 мкм. Слишком большие размеры и высокая плотность эритроцита обуславливает сложность прохождения через капилляры. Это — причина формирования сжатий. В клеточной оболочке возникают крупные касательные и растягивающие напряжения каплевидной формы. Образования разрушают клеточную структуру по экватору. Расслоенный эритроцит превращается из мишеневидного в звездчатую клетку.
Деформация мембраны
Эритроциты в анализе крови
Эритроциты мишеневидного типа в образце периферической крови возникают, когда величина периферической клеточной мембраны становится больше, чем количество гемоглобина, содержащегося в ней. Поэтому мишеневидные частицы обозначают рост клеточной мембраны у пациентов с печеночными заболеваниями, при гипохромии и железодефицитной анемии третьей степени, когда концентрация внутриклеточного гемоглобина падает. Это явление встречается у людей с пойкилоцитозом, анизоцитозом, талассемией и дефицитом железа.
Появление мишеневидных эритроцитов и измененных лейкоцитов характерно для анализа крови больных с некоторыми разновидностями регенеративных нарушений гемоглобина. К примеру: аномальным считается гемоглобин С и S. В такой ситуации деформированные клетки формируются из-за агрегации нездорового гемоглобина. Эти заболевания появляются и у ребенка, и у взрослого.
Анализ
Причины возникновения патофизиологии клеток
При болезнях печени мишеневидные клетки формируются из-за высокого скопления липидов на мембранных стенках эритроцитов. Это увеличивает размеры поверхности клетки по отношению к цитоплазме. В отличие от клеток мишеневидного типа, появляющихся при талассемии, называемых «микроцитами», деформированные эритроциты при печеночных патологиях являются макроцитами. Средний объем таких клеток составляет 110 фл.
Сильнее всего на формирование макроцитов влияет алкоголизм. Этот процесс не зависит от заболевания печени или недостатка кобаламина или фолата. Здесь причина в деформации мембранных стенок эритроцитов, связанных с альдегидными частицами – веществами, образующимися из-за деятельности этанола.
Эхиноциты обладают маленькими зубчиками, покрывающими поверхность эритроцитной мембраны. Несмотря на то, что данные клетки попадаются в образцах крови редко, особенно если в ней мало альбумина, эхиноциты обнаруживаются при острой печеночной и почечной недостаточности.
Читайте также: Пойкилоцитоз в общем анализе крови – причины, в чем опасность патологии и к чему она приводит
Способы лечения
Мишеневидные эритроциты, появившиеся на фоне алкогольной зависимости или избытка соли в организме, -я серьезная проблема. Поэтому решать ее нужно сразу после, как поставлен диагноз. Если игнорировать явление, то в клеточной оболочке в дальнейшем наблюдаются растягивающие напряжения, что приводит к разрушению эритроцитов. Достигнув зрелости, мишеневидные эритроциты трансформируются в звездчатые клетки, а состояние здоровья усугубляется.
Для лечения назначаются сборы трав на основе липы и ромашки. В некоторых случаях прописывают медикаментозные препараты, обеспечивающие улучшение состояния больного.
Оставляя патологию без лечения, пациент рискует получить серьезные заболевания печени. Поэтому к показателям анализов нужно относиться серьезно. Чем раньше начать лечение, тем проще побороть патологические процессы в организме.